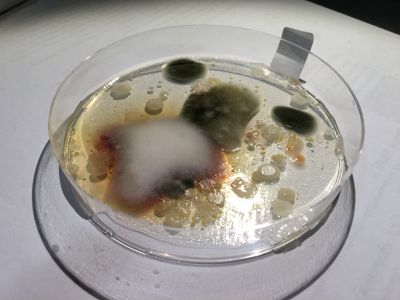

Das BioArt Seminar bietet eine gute Grundlage um neue Techniken und naturwissenschaftliches Wissen zu erarbeiten. Besonders die Arbeit mit Bakterien, Kristallen und Pilzen bietet viel Potenzial. Ebenso interessant sind die künstlerischen Arbeiten in Bezug auf Bioart. Wissenschaft und Kunst verschmelzen bei dieser Kunstform miteinander. Viele Künstler kommen aus naturwissenschaftlichen Bereichen und bringen neuen Input. Ebenso versuchen sich etablierte Künstler als Forscher und beschreiten dabei neue Wege, wodurch ganz neue Einblicke in gesellschaftliche, ethische und soziale Bereiche eröffnet werden.
Kurs
Beim ersten Treffen im Bauhaus DIY Labor überzeugt vor allem die vorhandene Technik. Zahlreiche Mikroskope, ein Inkubator und ein Sterilisator ermöglichen ein hervorragendes Arbeiten. Besonders das Dunkelfeldmikroskop in Kombination mit einer Spiegelreflexkamera ist interessant. Die Konservierung und Digitalisierung von Mikroorganismen mithilfe des Mikroskops war ein guter Einstieg. Diese Aufnahmen dienen zunächst als Experiment, um neue ästhetische Strukturen zu erkennen. Im weiteren Verlauf können die Videos und Fotos jedoch auch für andere Projekte genutzt werden. Des Weiteren begannen wir bereits in der ersten Sitzung Nährboden für Bakterienkulturen herzustellen. Dieser Nährboden wurde mit verschiedenen Bakterienkulturen versetzt.
Nach einer Woche konnte man bereits deutlich den Wachstum der Bakterienkulturen erkennen. Diese Strukturen lassen sich besonders gut unter dem Mikroskop erforschen.
Man erkennt deutlich farbliche Unterschiede zwischen den einzelnen Kulturen, ebenso sind die Wachstumsunterschiede zu verzeichnen. Interessant war auch der Theorieteil, welcher die Entwicklung vom Urknall bis zum heutigen Menschen umfasst. Besonders spannend ist hierbei die Frage, wie überhaupt Leben entstehen konnte. Die Symbiose aus Kunst und Wissenschaft wird bei diesen Konversationen besonders ersichtlich. Anschließend produzierten wir Mithilfe von Bakterienkulturen Jogurt und Kombucha Tee.
Das Kombucha und Jogurt Experiment war geglückt. Es zeigt sehr deutlich wie präsent Mikroorganismen in unseren alltäglichen Leben sind. Nur weil manche Dinge nicht gesehen werden, heißt das nicht, dass sie nicht von Bedeutung sind. In diesem Kurs beschäftigt mich zunächst die Züchtung von Biolumineszenzbakterien. Im Weitern Verlauf wurde uns gezeigt, wie man unterschiedliche Bakterienstämme isolieren kann. Bakterien sind ein sehr interessantes Spektrum, allerdings bedarf es einiger Kenntnisse um die verschieden Stämme unterscheiden zu können und ein jeweils gut geeignetes Medium zu finden. Hierbei spielt vor allem der Ph Wert des Mediums eine entscheidende Rolle.
Als nächstes setzten wir uns mit verschiedenen Pilzkulturen auseinander. Pilze sind einzigartige Lebewesen, meistens kennen wir nur die Pilzkörper. Ein wesentlich größerer Teil, nämlich das Myzel bleibt meist unentdeckt. Mithilfe von Myzel gehen Pilze Symbiosen mit anderen Pflanzen ein und tauschen Mineralsalze und Spurenelemente gegen Zucker. Pilze sind ein weites und noch nicht vollständig ergründetes Forschungsfeld. Es gibt noch viele unentdeckte Spezies, welche alle unterschiedliche Eigenschaften besitzen, welche für die Wissenschaft nicht unbedeutend sind (siehe Penicillin). Beispielsweise wurde bei Schleimpilzen eine gewisse Intelligenz festgestellt. Schleimpilze suchen sich immer den kürzesten Weg zur Futterquelle, die hierbei errichteten Myzelnetzwerke sind äußerst komplex und effektiv. Teilweise werden Schleimpilze zur Hilfe genommen um Bahnlinien oder ähnliches auf ihre Effektivität zu testen.
Es ist wichtig sich mit den Verhaltensweisen, der jeweiligen Organismen genau zu beschäftigen. Erst durch genaue Beobachtungen kann man verstehen, wie sich einzelne Lebewesen an ihre Umgebung angepasst haben. Um die Lebewesen gezielt zu beeinflussen, oder sie für künstlerische oder wissenschaftliche Zwecke zu nutzen bedarf es genauer Studien. Beispielsweise ist es möglich Euglena mithilfe von Licht zu steuern. Eugelenas haben einen Lichtpunkt, mit dessen Hilfe sie die lichtstärksten Orte ihres Habitats finden. Hierdurch ist es möglich Euglena zu lenken.
Besonders an solchen Punkten wurde die Frage aufgeworfen, wie weit solche "niederen Organismen" beeinflusst oder manipuliert werden dürfen. Ist es okay einen Hasen fluoreszierenden Eigenschaften zu verleihen, indem man seine DNA manipuliert. Darf man einer Kakerlake die Fühler abschneiden und mithilfe von Elektroden steuern?
http://www.chip.de/news/RoboRoach-Kakerlake-mit-Bluetooth-fernsteuern_64943439.html
In wie weit sollte man einen Organismus überhaupt manipulieren? BioArt stellt hierbei viele Fragen, welche im öffentlichen Diskurs normalerweise keinen Niederschlag finden.
Durch die technische Weiterentwicklung der letzten Jahre wird es möglich teure Apparate selbst nachzubauen oder diese gebraucht zu erwerben. Dies bietet vielen Wissenschaftlern, Künstlern und Privatpersonen selbständig zu forschen. DIY Labore spriessen weltweit aus dem Boden. Viele experimentieren in Bereichen, welche sie interessieren. Hierbei entstehen teilweise neue Resultate und sie tragen zum Erkenntnisgewinn bei. Allerdings können in diesen DIY Laboren auch DNA Manipulation stattfinden. In manchen Ländern sind die gesetzlichen Regelungen niedriger als in der EU. Klonen und die Veränderung der Erbinformation ist dadurch legal. Inwieweit diese DIY Labore die komplexen Prozesse umsetzen und vertretbar sind ist fraglich. Allerdings zeigen diese Labore, das auch Laien wissenschaftliche Erkenntnisse erarbeiten können und ein Expertenwissen aneignen können.
Am Ende des Kurses wurde auch eine DNA Analyse durchgeführt. Durch Entnahme von verschieden Fleischprodukten konnte man diese Anhand der enthaltenen DNA überprüfen, von welchem Tier es stammt. Abgesehen von der Zentrifuge, sind alle Geräte aus einem DIY Workshop. Daran erkennt man deutlich, wieviele Möglichkeiten man zur Umsetzung verschiedenster BioArt Projekte man besitzt.
File:Heating/cooling block.JPG 




Eigenes Projekt - BREAK THE SILENCE
Bereits zu Beginn des Seminars fanden mehrere Experimente in Bezug auf Kristallwachstum statt. Kristallwachstum ist ein faszinierender Prozess, wobei viele Faktoren wie Temperatur, Salzart, Druck und Zeit eine Rolle spielen. Kristalle zählen nicht zu den Lebewesen, allerdings haben sie gewissen Eigenschaften, welche dies vermuten lassen.
Inspiration:
Tokujin Yoshioka – Chrystalize
- Chrystal growing with Music (Tchaikovsky’s ballet, Swan Lake)
Break the silence
Die Kristallisation ist ein faszinierender Prozess bei dem unzählige Einzelfaktoren eine Rolle spielen. In einem ruhigen Habitat lagern sich jede Sekunde hunderte Teilschichten an einem dreidimensionalen Kristallgitter ab. Hochgradig geordnet und regelmäßig strukturiert
Aus Chaos wird Ordnung.
Dieser Ordnungsprozess wird jedoch mit einer niedrigen Frequenz kontinuierlich gestört. Vibrationen und Pulsieren nehmen ständigen Einfluss auf den Kristallwachstum und diktieren ihm eine neuen Form auf. Durch diese Manipulation entstehen neue Kristallverbindungen, Wachstumsinstabilitäten und/oder Mutationen.
English:
Crystallization is a fascinating process in which innumerable individual factors play a role. In a quiet habitat, hundreds of partial layers are deposited on a three-dimensional crystal lattice every second. Highly ordered and regularly structured.
Chaos becomes order.
This order process is continuously interfered with a low frequency. Vibrations and pulsations are a constant influence on crystal growth and dictate to it a new form. This manipulation creates new crystal compounds, growth instabilities and / or mutations.
Theorie:
„Kristallwachstum ist der kontinuierliche Prozess des Größerwerdens eines Keims bis zum fertigen Kristall“1 Die Kristallisation ist ein komplexer Vorgang, der sowohl vom Zustand der wachsenden Kristallfläche als auch vom Zustand der molekularen Bausteine in der Nährphase und den Umgebungsbedingungen abhängt.2 Kristallwachstum beschreibt daher die geordnete Zusammenlagerung von Atomen, Molekülen oder Ionen. Schicht für Schicht entsteht ein dreidimensionales Gitter, wobei die Gitterkräfte eine entscheidende Rolle spielen.3
Aus Chaos entsteht Ordnung!
Konzept:
Normalerweise wachsen Kristalle am besten in einer erschütterungsfreien und ruhigen Umgebung. Hierbei entstehen gleichförmige und gleichmäßige Kristallstrukturen. Dieser Prozess wir jedoch im folgenden Bioart Projekt durchbrochen. Mithilfe von niedrigen Frequenzen wird Einfluss auf das Kristallwachstum genommen werden. Durch diese Manipuliation entstehen neue Kristallverbindungen, Wachstumsinstabilitäten oder Mutationen.
Umsetzung:
Die Grundidee ist es, das Kristallwachstum mithilfe von Bassfrequenzen zu beeinflussen. Dies erfolgt über einen modifizierten Subwoofer, welcher genau auf die Bedingungen abgestimmt wurde. Dadurch werden die elektroakustischen Signale der Audioquelle auf eine Glasschale übertragen. In dieser Glasschale befindet sich eine gesättigten Lösung aus Kupfer (II) Sulfat. Der natürliche Kristallwachstum wird dementsprechend durch die Basswellen, Schallwellen und Vibrationen beeinflusst und entspricht nicht den „normalen“ Wachstumsbedingungen eines Kristalls.
Wissenschaftlicher Bezug:
Das Wachstum von Kristallen stellt die Wissenschaft noch immer vor viele Rätsel. Besonders dann, wenn Kristalle unregelmäßig von der ursprünglich symmetrischen Form wachsen.4
Wissenschaftler der Universität Konstanz berichten, dass sie auf Nano-Ebene nachweisen konnten, damit die Natur eine Vielzahl an Varianten des Kristallwachstums abseits der klassischen Methode „ein-Atom-nach-dem-anderen“ kennt.5
Durch die Untersuchung des Kristallwachstums kann man Rückschlüsse auf andere wichtige Ordnungsprozesse der Natur ziehen.6
„Jenseits der Edelsteine spielt das Kristallwachstum auch eine bedeutende Rolle für eine Vielzahl an Materialien und Anwendungen in allen Bereichen, vom biologischen Skelett und Muschelschalen über geologische Bodenschichten bis hin zur Halbleiter-Technologie. Über mehrere Fachrichtungen hinweg haben Wissenschaftler Phänomene des Kristallwachstums beobachtet – so zum Beispiel anhand des Skeletts von Tieren oder in Laborexperimenten -, die sich nicht durch klassische Theorien erklären lassen.“7
1https://www.mineralienatlas.de/lexikon/index.php/Kristallwachstum).
2 http://www.spektrum.de/lexikon/geowissenschaften/kristallwachstum/8919
3http://daten.didaktikchemie.uni-bayreuth.de/experimente/effekt/photo_kristalle.htm
4 http://www.grenzwissenschaft-aktuell.de/neue-gesetze-kristallwachstum20150803/
5 vgl. ebd.
6 http://www.zeit.de/1997/03/Mathematik_der_Kristalle
7 http://www.grenzwissenschaft-aktuell.de/neue-gesetze-kristallwachstum20150803/
Dokumentation der Test- und Versuchsphasen:
Endergebnis
Ausstellung:
Shared Matters